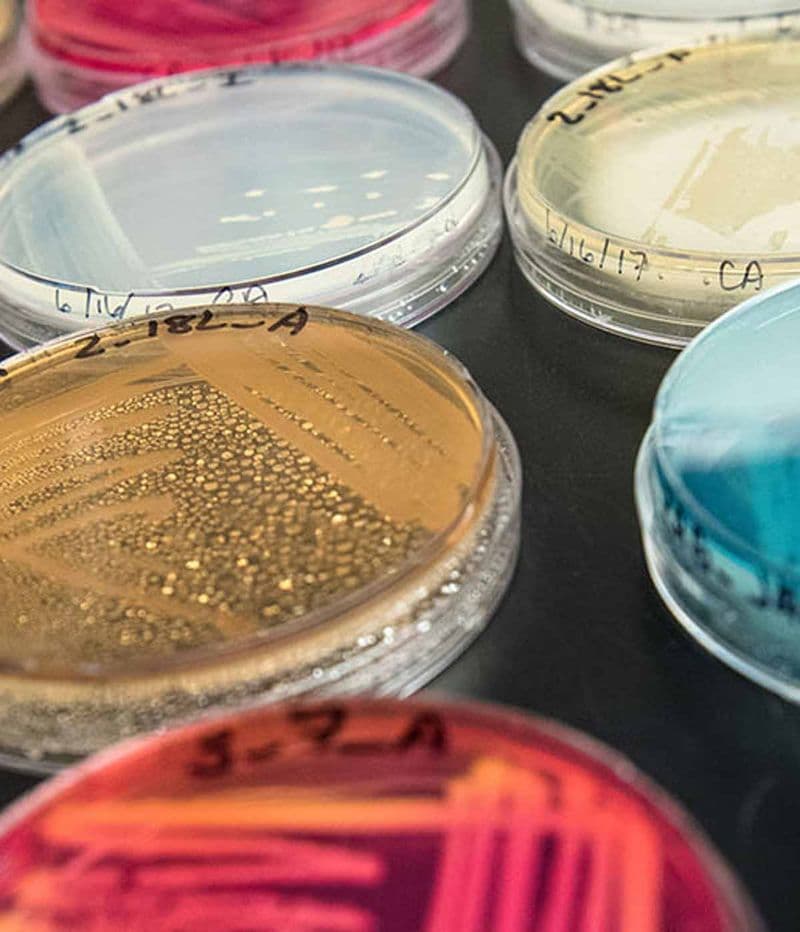

Gonzaga University: Undergraduate International Programs

Gonzaga University humanistic background places a strong emphasis on teaching the whole person, including the intellect, body, and spirit, as well as fostering progress in all spheres of life, including academic, professional, and personal development.
- #79 National Universities- U.S. News and World Report, 2022
- #13 Undergraduate Teaching- U.S. News and World Report, 2022
Degrees: Undergraduate Degrees
Gonzaga University Global offers 49 majors, more than 60 minors, and 50 different concentrations to overseas students. Engineering, business, accounting, finance, and computer science are popular, highly rated programmes.
College of Arts & Sciences
The College Arts & Sciences offers bachelor’s degrees across the humanities, arts, natural sciences, and social sciences. Gonzaga believes a strong liberal arts foundation fosters scholarly inquiry, creativity, and collaboration.
- Applied Mathematics
- Art (B.F.A.)
- Biochemistry (B.S.)
- Biology (B.A)
- Biology (B.S.)
- Broadcast and Electronic Media
- Chemistry (B.A.)
- Chemistry (B.S.)
- Classical Civilizations
- Communication Studies
- Computer Science & Computational Thinking
- Criminology
- Dance
- Economics—Arts
- Economics—Science
- English–Literature/Writing
- Environmental Studies
- French
- History
- International Studies—Asian Studies
- International Studies—European Studies
- International Studies—Latin American Studies
- Italian Studies
- Journalism
- Mathematics (B.A.)
- Mathematics (B.S.)
- Music
- Music Education
- Philosophy
- Physics (B.A.)
- Physics (B.S.)
- Political Science
- Psychology
- Public Relations
- Religious Studies
- Sociology
- Spanish
- Theatre Arts
School of Business Administration

Gonzaga University School of Business Administration — ranked in the Top 100 for undergraduate business programs (U.S. News & World Report, 2021) — creates global leaders who think critically, solve problems creatively, and lead boldly.
- Accounting
- Business Administration
- –Economics
- –Entrepreneurship and Innovation
- –Finance
- –Human Resource Management
- –Individualized Study
- –International Business
- –Law and Public Policy
- –Management Information Systems
- –Marketing
- –Operations and Supply Chain Management
School of Education

Gonzaga University School of Education creates inspirational classroom leaders who serve with care, competence, and a commitment to the common good.
- Community, Culture and Language in Education
- Kinesiology– Fitness Specialist/Health and Education Pedagogy
- Special Education
- Sport Management
- Undeclared Education
School of Engineering & Applied Sciences

The School of Engineering & Applied Sciences aims to shape intellectual curiosity, analytic skills, and humanitarian outlook. Gonzaga’s undergraduate engineering program is ranked #23, #15 for civil engineering, and #27 for mechanical engineering by U.S. News & World Report (2021).
- Civil Engineering
- Computer Engineering
- Computer Science
- Electrical Engineering
- Engineering Management– MBA option
- Mechanical Engineering
- Pre-Engineering
- Undeclared Engineering
School of Nursing & Human Physiology

The School of Nursing & Human Physiology provides opportunities to serve vulnerable populations, research with exemplary faculty, and engage with local, national, and international health communities with Gonzaga University.
- Human Physiology
- Nursing
Tuition & Cost
Tuition, housing, dining, and other fees vary by degree program, housing location, and preferences.
Tuition- $51,266
Housing- $6,780
Dining- $6,260
Other- $2,100
Total- $66,406
Typical cost for two semesters.
Housing

Typical housing fees for one academic year is $6,780.
[Housing prices vary based on room choice, amenities, and program track. Your preference is taken into account, but preferred pick is not guaranteed.]
How To Apply
We offer a streamlined application process for international students.

- Complete your application-Our advisors walk you through everything you need – transcripts, English scores, passport, and more.
- Submit additional documentation-Once you receive a final admission letter, you will need to submit your I-20 request form, certification of finances, and other paperwork.
- Apply for your F-1 student visa-Our staff guides you through the visa application process and helps you prepare for your visa interview, too.
Ask Foreign Admits.
1. What is the average SAT score for admitted students?
Mid-50% range 1250-1390.
2. What is your acceptance rate?
67% (Average 2019-2023)
3. How much does it cost to attend Gonzaga?
Full-time (12-18 credits) Undergraduate Tuition: $47,560 per year
Part-time: $1,585 per credit hour
Meal Plan – $6,270 per year
Double occupancy room – $6,922 per year (weighted average of room options)
Miscellaneous Fees, Books, and Supplies: Varies
Conclusion
Gonzaga University is known for its excellent undergraduate programs in several aspects. The college offers the best degree programs that cater to the diverse needs of international students. With a top-notch faculty and state-of-the-art facilities, this college has become a hub for quality education in the country. So, enroll yourself in the upcoming July and join the next batch of August 2023.
